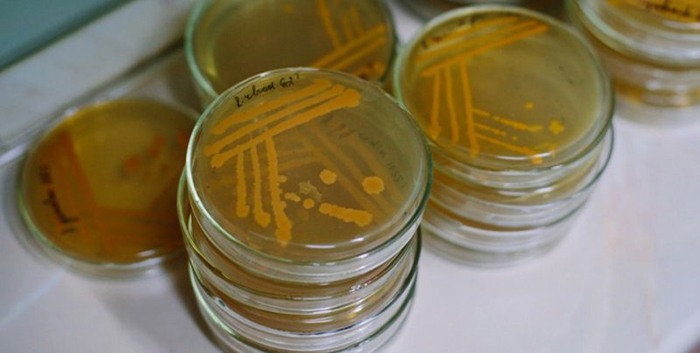

Дисбактериоз представляет собой нарушение баланса полезных бактерий в микрофлоре кишечника. Анализ кала на дисбактериоз – дисбиоз кишечника – проводится с целью выявления изменений в кишечнике как качественного, так и количественного характера, а также для определения соотношений микроорганизмов и выявления степени патологического процесса. Этот анализ помогает определить оптимальное лечение: диетическое, пробиотическое, антибактериальное.
Неотъемлемыми элементами данного исследования являются методы количественного исследования и анализ множества векторов (определение всех микроорганизмов микрофлоры), сравнение полученных результатов с клиническими данными пациента и его возрастом.
Показания к сдаче анализов
Причинами для прохождения анализа могут быть:
- Длительные нарушения работы кишечника, такие как понос, запор и избыточное газообразование.
- Прошедший через организм кишечный инфекционный процесс.
- Лечение гормонами.
- Применение химиотерапии.
- Курс приема противобактериальных препаратов.
- Перед проведением операции.
- При наличии аллергии, такой как бронхиальная астма или атопический дерматит.
Младенцам до года необходимо проходить анализы в следующих ситуациях:
- Получила инфекцию еще до рождения.
- Использование искусственных смесей для кормления.
- Непереносимость грудного молока.
- Замедленный набор веса или его резкое снижение.
- Частые заболевания дыхательных путей.
- Воспаление слизистой оболочки рта.
- Кандидозная инфекция.
Виды анализов
Способы изучения для обнаружения дисбактериоза:
Копрограмма
В лаборатории проводятся макроскопические, химические и микроскопические исследования кала. При макроскопическом анализе образец изучается на предмет цвета, запаха, текстуры и наличия остатков непереваренной пищи. По запаху и цвету можно определить наличие крови, слизи, а также неправильное переработку белков и жиров, поступающих с пищей.
При проведении химического анализа осуществляется проверка на наличие крови в фекалиях, что способствует выявлению потери крови в желудочно-кишечном тракте, наличия полипов и варикозного расширения вен. Микроскопическое исследование позволяет выявить наличие в биоматериале мышечных волокон и непереваренной клетчатки.
Бактериологический анализ
Демонстрирует наличие вредоносных микроорганизмов: сальмонелл, дизентерийных бацилл, синегнойных бактерий. В норме эти микроорганизмы не должны присутствовать в организме человека. Их размножение и рост вызывают нарушения пищеварения и в целом отрицательно воздействуют на организм.
Метод посева
Метод микрохимического анализа основан на посеве образца на специальную питательную среду. Для изучения различных микроорганизмов применяется питательная среда определенного состава. Этот метод позволяет обнаружить наличие микроорганизмов и оценить степень дисбактериоза.
Подготовка и забор материала для анализа
Назначение диеты, требующей воздержания от определенных продуктов, происходит за четыре дня до проведения анализа у пациента.
- Использование алкоголя.
- Употребление острой пищи.
- Применение антибактериальных препаратов.
- Использование слабительных средств.
- Использование вазелина.
- Использование ректальных свечей.
- Применение любых клизм.
- Использование касторового масла.
Важно придерживаться определенных правил при сборе биоматериала:
- Перед взятием образца биоматериала должно пройти не менее 80 часов после последнего приема пищи. Сбор образца должен происходить естественным образом, без использования слабительных препаратов.
- Для забора образца кала используется стерильный контейнер, в который помещается специальная ложечка. Такой контейнер можно получить в лаборатории или приобрести в аптеке.
- Перед процедурой сбора образца необходимо провести гигиеническую обработку области без использования мыла или геля, чтобы исключить попадание посторонних элементов в образец.
- Сначала производится сбор образца мочи, затем материал собирается в контейнер: сосуд, пленку или подгузник. Необходимо взять небольшое количество материала из разных частей без касания дна. Важно избежать попадания мочи или части подложки в образец.
- Для проведения анализа необходимо собрать не менее 2 граммов фекалий, что примерно соответствует 8 ложечкам, прилагаемым к контейнеру. Объем собранного материала не должен превышать 1/3 объема контейнера.
- Контейнер должен быть герметично закрыт, так как контакт с воздухом может негативно повлиять на аэробные микроорганизмы. На контейнере следует указать ФИО пациента, дату рождения и время сбора образца.
- Образец должен быть доставлен в лабораторию в течение 3 часов после сбора. Чем дольше проходит время до доставки образца, тем сильнее искажается результат будущего анализа.
- Температура образца во время транспортировки не должна превышать +2 градуса. Замораживать образец кала не допускается, так как неправильное хранение может повлиять на результаты исследования.
Результаты и расшифровка
В документе с результатами анализа указаны стандартные значения для каждого обследованного вида бактерий. У новорожденных, детей старше года и взрослых уровни могут различаться. Вы можете самостоятельно сопоставить полученные данные с нормой, но консультация врача поможет более подробно проанализировать состояние микрофлоры кишечника. Дальнейшие изменения можно отслеживать самостоятельно.
Рекомендации для малышей до одного года/ после года и для взрослых:
- Энтеробактерии, вызывающие заболевания – 0 / 0
- Кишечная палочка, вызывающая гемолиз – 0 / 0
- Кишечная палочка – 300-400 миллионов/грамм / 400-1 миллиард/грамм
- Кокковые формы в общей массе микроорганизмов – менее или равно 25% / менее или равно 25%
- Стафилококки – менее или равно 10 в степени 4 / менее или равно 10 в степени 4
- Золотистый стафилококк – 0 / 0
- Бифидобактерии – от 10 в степени 10 до 10 в степени 11 / от 10 в степени 9 до 10 в степени 10
- Лактозонегативные энтеробактерии – менее или равно 5% / менее или равно 5%
- Лактобактерии – от 10 в степени 6 до 10 в степени 7 / от 10 в степени 7 до 10 в степени 8
- Клостридии – менее или равно 10 в степени 5 / менее или равно 10 в степени 3
- Эубактерии – от 10 в степени 6 до 10 в степени 7 / от 10 в степени 9 до 10 в степени 10
- Дрожжеподобные грибы Candida – менее или равно 10 в степени 3 / менее или равно 10 в степени 4
- Бактероиды – от 10 в степени 7 до 10 в степени 8 / от 10 в степени 9 до 10 в степени 10
- Пептострептококки – менее 10 в степени 5 / от 10 в степени 9 до 10 в степени 10
- Энтерококки – от 10 в степени 5 до 10 в степени 7 / от 10 в степени 5 до 10 в степени 8
Частые вопросы
Какие виды анализов используются для диагностики дисбактериоза?
Для диагностики дисбактериоза обычно используют анализ кала на дисбактериоз, который позволяет определить количество и состав микроорганизмов в кишечнике. Также могут применяться анализы крови и мочи для выявления патологий, связанных с нарушением микробиоценоза.
Как правильно сдавать анализы на дисбактериоз?
Для анализа кала на дисбактериоз необходимо собрать утреннюю порцию кала в специальный контейнер, предварительно избегая контакта с мочой. Перед сбором кала следует воздержаться от приема лекарств, содержащих антибиотики, и проконсультироваться с врачом относительно возможности приостановки приема пробиотиков и пребиотиков.
Какие показания для сдачи анализов на дисбактериоз?
Показаниями для сдачи анализов на дисбактериоз могут быть различные жалобы пациента, такие как нарушения пищеварения, частые боли в животе, поносы или запоры, а также после приема антибиотиков или других лекарств, способствующих нарушению микрофлоры кишечника.
Полезные советы
СОВЕТ №1
Перед сдачей анализов на дисбактериоз следует воздержаться от приема антибиотиков, пробиотиков и препаратов, содержащих желчные кислоты, в течение 2 недель, чтобы получить более точные результаты.
СОВЕТ №2
Для анализа на дисбактериоз обычно берется кал, поэтому важно соблюдать правила сбора и хранения образца, указанные лабораторией, чтобы избежать искажения результатов.
СОВЕТ №3
При подготовке к сдаче анализов на дисбактериоз следует избегать приема препаратов, влияющих на микрофлору кишечника, таких как слабительные, противогрибковые и противовоспалительные средства, в течение нескольких дней до сдачи анализа.